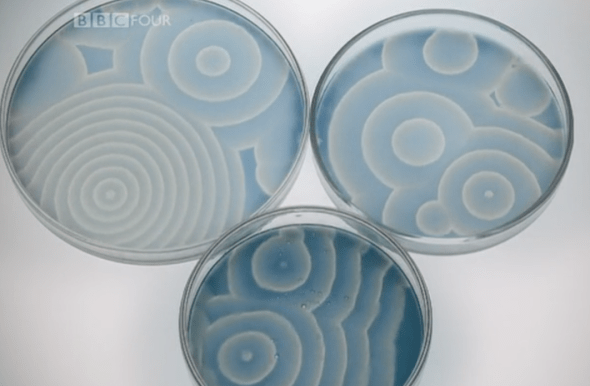
self org patterns.png

jim al-khalili
intro’d to Jim while watching the secret life of chaos doc (2010) 60 min – found on top documentary site:
http://topdocumentaryfilms.com/secret-life-chaos/
a film about one very simple question.. how did we get here
2 min – there is a strange and unexpected relationship between order and chaos..
3 min – the natural world really is one great blooming buzzing confusion.. a mess of quirky shapes/blotches… what patterns there are are never quite regular.. and never seem to repeat exactly..the idea that all this mayhem.. all this chaos.. is underpinned .. indeed determined.. by mathematical rules and that we can work out what those rules might be.. runs counter to our most dearly held intuitions..
4 min – alan turing – first man to really take on tremendous task of unraveling nature’s mysterious mathematics had a very special/unusual mind.. both a great scientist and a tragic hero.. born 1912 in london.. discovered many of foundamental ideas that underpinned the modern computer
code breaking.. his contribution.. saved thousands of lives.. but just one part of his genius.. of seeing patterns hidden to rest of us
5 min – ian stewart (https://en.wikipedia.org/wiki/Ian_Stewart_(mathematician)): turing was first to realize.. simple math equ…
6 min – andrew hodges (https://en.wikipedia.org/wiki/Andrew_Hodges): inspired this research by death of his love.. very emotionally disturbed.. but wanted to put it in an intellectual/scientific context .. and the question he wanted to put in sci context was: what happens to the mind.. what is it…
turing became convinced that math models could be used to describe bio systems.. and ultimately.. intelligence.. this fascination would give rise to the modern computer… and later in turing’s life.. the idea that you could have math description for morphogenesis (https://en.wikipedia.org/wiki/Morphogenesis) – at first all cells in embryo are identical..then.. cells clump together.. and also become different from each other..
7 min – how does this happen.. w/no thought.. no central coord.. how do cells that start off identically know to become.. say.. skin… while others become part of an eye
morphogenesis is a spectacular ie of something called self-organization.. .and before turing.. no one had a clue how it worked..
1952 – turing publishes paper (chemical basis of morphogenesis).. with the world’s first mathematical explanation for morphogenesis…. staggering..
8 min – andrea sella (@sellathechemist) (https://en.wikipedia.org/wiki/Andrea_Sella): one of astonishing things about turing’s work.. was that starting with description of very simple processes that were governed by very simple equations.. by putting these together.. suddenly.. complexity emerged.. the patterns suddenly came out as a natural consequence… very unexpected
9 min – in essence turing’s equations .. familiar.. just not in context of biology..
11 min – now know.. morphogenesis is much more complicated than turing’s equations.. still quite debatable.. but turing’s idea.. that whatever is going on.. is deep down a simple mathematical process was truly revolutionary
12 min – andrea: turing’s paper.. probably the cornerstone in the whole idea of how morphogenesis works.. provides us with a mech.. for how pattern emerges (that darwin didn’t)
13 min – turing was onto a big idea.. but sadly.. could only speculate how/where his mind would have taken it.. because shortly after his groundbreaking paper on morphogenesis.. a dreadful and completely avoidable tragedy destroyed his life… choice of prison our female drugs.. female drugs sent him into depression.. he died age 41.. loss to science incalculable..
15 min – looking back.. we now know.. turing had really grasped the idea that the wonders of creation had really derived from the simplest of rules.. first step to a new kind of science..
16 min – 50s.. a nother tragic story.. behind the iron curtain.. boris belousov (https://en.wikipedia.org/wiki/Boris_Pavlovich_Belousov) .. on glucose absorption in the body… glucose in water… color oscillations.. as if driven by some chemical metronome… clear to colored and back again.. publication refused…
19 min – rejection crushed him.. and divided by iron curtain.. belousov never encountered turing’s work.. if he had.. he would have been completely vindicated.. turns out.. belousov’s oscillating chemicals.. far from contravening laws of physics… where actually a real world ie of precisely the behavior turing’s equations predicted
20 min – in fact.. other scientists find.. if left alone .. w/o stirring.. liquids create stunning self-org shapes.. out of nowhere..
andrea: the amazing.. very unexpected thing about the belousov reaction.. is that someone had discovered a system which essentially reproduces the turing equations.. and so from what looks like a very very bland solution emerged these astonishing patterns..waves.. scrolls.. and spirals..
21 min – this is emphatically not abstract science.. the way belousov’s chemicals move as coordinated waves is exactly the way our heart cells are coordinated as they beat… animal skins and heart beats… self-org seems to operate all over the natural world
so why were the scientific community in turing’s day so uninterested.. or even hostile to this astonishing and beautiful idea.. well.. the reason was all too human: mainstream scientists simply didn’t like it..
to them it seemed to run counter to science.. and all that it had achieved… to change that view would require a shocking and completely unexpected discovery…
22 min – in essence.. by the beginning of the 20th cent.. scientists saw the universe as a giant complicated mechanical device.. the idea.. that universe was huge.. intricate machine.. that obeys orderly mathematical rules… if you knew the rules of how the machine was configured to start with.. as you turn the handle over and over again.. it will behave in an entirely predictable way
23 min – ian: back in times of isaac newton when people were discovering the laws that govern the universe.. they came up with this kind of metaphor of a clockwork universe… the universe looked like a machine.. a complicated machine.. that followed the rules.. and complicated things happened.. but once you set it going.. it would only do one thing.. the message from this: anything describable by mathematical rules must actually basically be very simple..
find the mathematics that describes a system and you can then predict how that system will unfold..
predict able ness
that was the big idea.. it began with newton’s law of gravity.. which could be used to predict how a planet moves around the sun.. scientists soon found many other equations.. just like it
newtonian physics seemed like the ultimate crystal ball.. it held up the tantalizing possibility that the future could in principle be known..
the more careful your measurements are today.. the better you can predict what will happen tomorrow..
24 min – but newtonianism had a dangerous consequence.. if a nice mathematical system that worked in a similar way to my orwawi (? – clock mech).. did sometimes become unpredictable.. scientists assumed some maligned outside force was causing it.. perhaps dirt had got in.. perhaps cogs were wearing out.. perhaps someone had tampered with it..
ian: basically.. we used to think.. if you saw very irregular behavior in some problem you’re working on this must be the result of some sort of random outside influence.. it couldn’t be internally generated.. it wasn’t an intrinsic part of the problem it was some other thing impacting on it..
deep enough ness..
25 min – looked at from this pov.. the whole idea of self-org seemed absurd..
the idea that patterns of the kind turing and belousov had found could appear of their own accord..
… without any outside influence was a complete taboo
25 min – the only way for self-org to be accepted (image of nasa blast off to the moon) was for the domineering newtonian view to collapse
but that seemed very unlikely.. after all.. by the late 60s it had delivered all the wonders of the modern age (placing flag on moon… to cocoon.. to satellite shot.. of hurricane ness)
but then.. at the same time as the moon mission.. a small group of scientists.. all ardent newtonians.. quite unexpectantly ..found something wasn’t right.. not right at all
26 min – during 2nd half of 20th cent.. a devil was found in the detail.. a devil that would ultimately shatter the newtonian dream and plunge us literally into chaos..
ironically.. the events that forced scientists to take self-org seriously.. was the discovery of the phenom known as chaos..t
carhart harris entropy law et al
chaos is one of the most overused words in english.. but in science it has a very specific meaning: it says that a system that is completely described by mathematical equations.. is more than capable of being unpredictable.. w/o any outside interference whatsoever..
27 min – robert may (https://en.wikipedia.org/wiki/Robert_May,_Baron_May_of_Oxford): a widespread mis apprehension that chaos is just somehow saying the very familiar fact.. that everything’s complicated.. the nitwit chaoticist to jurasic park was under that confusion.. something much simpler.. and yet much more complicated than that.. it says: some very very simple rules or equations.. with nothing random in them.. completely determined.. we know everything about the rule.. can have outcomes that are entirely unpredictable..
chaos is one of the most unwelcome discoveries in science.. the man who forced the scientific community to confront it was an american meteorologist.. edward lorenz (https://en.wikipedia.org/wiki/Edward_Norton_Lorenz) (coined the term.. butterfly effect)… in the early 1960s.. he tried to find math eq’s that could help predict the weather.. like all his contemporaries.. he believed that in principle.. the weather system was no diff to my orary (?).. a mechanical system that could be described and predicted mathematically.. but he was wrong
28 min – when lorenz wrote down what looked like perfectly simple math eq’s to describe the movements of air currents.. *they didn’t do what they were supposed to.. they made no useful predictions whatsoever..
the craziness of supposed to ness for self-org systems.. like people.. like turing.. like deciding who a person can/should love.. like deciding who we should listen to.. who we should keep quiet..
oy
it was as if the lightest breath of air one day.. could make the diff a month later.. between a snow storm and a perfectly sunny day
how can a simple system.. that works in a regular clockwork manner.. become unpredictable.. it’s all down to how it’s configured.. how the gears are connected.. in essence.. under certain circumstances.. the tiniest diff in the starting positions of the cogs.. diff’s that are too small to measure.. can get bigger and bigger with each turn of the handle..
now sounding like.. copy of copy of copy.. rna ness toward cancer (it can go toward good .. just hasn’t yet)
so.. what we’re needing is some kind of detox/do-over to get our rna back to a close ness to dna.. then.. finally.. let go.. and just see..
29 min – with each step in the process.. the system then moves further and further away from the way it thought it was going.. lorenz captured this radical idea in an influential talk he gave called: does the flap of a butterfly’s wings in brazil set off a tornado in texas..
it was a powerful/evocative image and w/in months.. a new phrase had entered our language.. the butterfly effect.. and the butterfly effect.. the hallmark of all chaotic systems.. started turning up everywhere..
30 min – in the early 70s.. a young australian called robert may.. was investigating a math eq that modeled how animal populations changed over time.. but here too.. lurked the dreaded butterfly effect.. immeasurably small changes to the rates to which the animals reproduced could sometimes have huge consequences on their overall population… numbers could go up and down wildly.. for no obvious reason..
the idea that a math eq gave you the power to predict how a system will behave was dead..t
predict able ness
31 min – robert: in some senses this was the end of the newtonian dream.. when i was a grad student.. the belief was.. as we got more and more computer power.. we’d be able to solve more and more complicated sets of eq’s.. but this said.. that’s not necessarily true.. you could have the simplest eq’s you could think of .. w nothing random in them.. and know everything.. and yet.. if they have behavior that gives you chaotic solutions.. then you can never know the starting point accurately enough..
now sounding like science of people – where we think/assume we know the starting point..
centuries of scientific certainty.. dissolved in just a few short years.. the truth of the clockwork universe turned out to be just an illusion… something that seemed a logical certainty.. revealed itself merely as an act of faith.. *and what’s worse.. the truth had been staring us in the face all the time.. because chaos is everywhere..
*and what’s worse.. truth screaming at us.. ie: suicides, war, et al… chaos of us.. crying out to be set free..
32 min – it seemed unpredictability was hard wired into every aspect of the world we live in.. the global climate.. the stock market.. could change in course of few short years.. without warning.. could be wiped from face of planet overnight (nuclear) and there was nothing anyone could do about it
unfortunately i have to tell you.. that all of this is true.. and yet..
to be scared of chaos is pointless..t
it’s woven into the basic laws of physics… and we really all have to accept it as a fact of life..
antifragile ness
carhart harris entropy law et al
ian: the idea of chaos really did have a big impact over a period of about 20-30 yrs because it changed the way everyone thought about what they were doing in science.. it change it to the point that they forgot that they’d ever believed otherwise.. what chaos did was to show us that the possibility inherent in the simple math were much broader/general than you might imagine..
fractal thinking..zoom dancing..
33 min – ian: and so .. a clock work universe can nonetheless behave in the rich complex way that we experience
the discovery of chaos was a real turning point
34 min – via turing/belousov/may/lorenz… incredible link between order and chaos… the very unpredictability is what makes the patterns/structure
35 min – unique property.. referred to as coupling.. or feedback.. order and chaos can emerge on their own from a simple system with feedback…
36 min – even though i can describe each step in teh process mathematically.. i have no way of predicting how tiny changes in the match flame.. will end up in the end.. this is the butterfly effect in action..
37 min – ian: the same mathematics is generating chaotic behavior and pattern behavior… not two diff… but two diff spectrums of same behavior
38 min – andrea: take home from turing’s work.. ultimately… pattern formation seems to be very woven deeply into the fabric of the universe.. pattern is everywhere.. it’s just waiting to happen
39 min – one man brought this more into play – benoit mandelbrot (https://en.wikipedia.org/wiki/Benoit_Mandelbrot) – never formally learned alphabet.. or even mult beyond 5 x table.. but like turing.. he had a gift for seeing nature’s hidden patterns.. he could see rules where the rest of us see anarchy.. he could see form/structure.. where the rest of us just see a shapeless mess… he could see that a new strain of mathematics.. underpinned the whole of nature..
mandelbrot’s lifelong quest was to find simple math basis for rought/irregular shapes of the real world
40 min – ian: mandelbrot was working for ibm.. not in the normal academic environment.. working on diff problems .. about irregularities .. in nature and the financial markets.. at some point it dawned on him that everything he was doing seemed to be really parts of the same big picture.. and he was a sufficiently original/unusual person that he realized that pursuing this big picture was what he really wanted to do..
fractal thinking..zoom dancing..
to mandelbrot is seemed perverse.. that mathematicians had spent centuries contemplating idealized shapes.. like straight lines.. and perfect circles.. and yet had no proper systematic way of describing the rough/imperfect shapes that dominate the real world..
41 min – mandelbrot asked if there’s something unique that defines all the varied shapes in nature.. do they share a common mathematical feature.. underlying all shapes.. is .. self-similarity…. branching/forking principal… repeating whole in smaller sizes.. ie: trees.. lungs..rivers..
43 min – could you use math to draw a picture that didn’t look manmade… armed with new breed of supercomputer (working at ibm) he began investigating
44 min – the mandelbrot set.. been called the thumbprint of god… the more you zoom in .. the more detail… via an equation.. that feeds back on itself.. each output becomes input for next.. so simple equation to infinite complexity…
45 min – fractal property at being similar at all scales mirrors a fundamental principle in nature..
46 min – turing’s patterns.. belousov’s reaction.. and mandelbrot’s fractals all signposts pointing to a deep underlying principle..
ian: when we look at complexities in nature we ask.. where did they come from.. there’s something in our heads that complexity does not arise out of simplicity.. it must arise thru something complicated… but really complex comes from simple eq’s.. we have to rethink relationship between simplicity and complexity..
complexity.. a means to make it simple enough
complex systems can be based on simple rules.. that’s the revelation..
ie: global systemic change.. based on 2 convers/needs…
ie: flock of birds.. each bird following simple rules.. but whole flock.. capable of complicated things.. no single leader.. or even conscious plan
stigmergic.. no agenda.. et al
47 min – amazing though this flocks behavior is.. it’s impossible to predict how it will behave.. it never repeats.. even in seemingly identical circumstances.. may look similar.. but never identical.. same true in video loops and sand patterns..
the big question is.. can nature’s ability to turn simplicity into complexity explain why life exists…
rather.. be question.. can we use this to detox ourselves.. back to being ourselves… rather than asking why life exists.. actually go back to existing..
49 min – process to hone this.. called evolution
ian: evolution has built on these patterns.. combined in various ways.. experimented to see what works and what doesn’t .. kept things that work.. et al…
50 min – the way evolution refines/enriches complex systems.. is one of most intriguing ideas in recent science…
torsten reil (@torstenreil): my interest was to see how complex systems interact with evolution.. on one hand systems that almost org themselves.. as complex systems.. so they exhibit order that you wouldn’t expect.. but on other hand.. still have to have evolution interact with that to create something that is truly adapted to the environment…
evolution’s mindless yet creative power to develop/shape complex systems.. is indeed incredible.. but it operates on a cosmic time scale.. we now have a device that can mimic that.. the computer.. can churn thru trillions of calcs per second.. gives them the power to simulate evolution.. use principles of evolution to shape/refine own programs.. in same way natural world uses to evolution to shape/refine living orgs.. today..this evolved software can solve problems that would be beyond the smartest of humans
52 min – (torsten): one thing we found.. is how powerful evolution is as a system/algo to create something that is very complex/adaptive
torsten goal.. to use computerized evolution to create a virtual brain that would control a virtual body.. to begin .. they created 100 random brains.. not up to much.. evolution then took over.. the computer selected the brains that were slightly better at moving their bodies.. and got them to breed
53 min – torsten: the algo then takes those individuals that do the best and it allows them to create offspring… eventually.. you end up with something that works .. the scary thing is .. you don’t know how/why it works.. you look at that brain and have no idea what’s going on.. because evolution has optimized it automatically..
if so.. why do we keep pushing for efficiency.. we should just let go and trust.. no?
53 min – after 20 generations.. could walk.. but then went on to do things that couldn’t be programmed conventionally.. they react realistically to unexpected events..
torsten: even though we control these algo’s.. when goes live.. does things we never expected.. it’s quite a funny feeling that you create these algo’s but then they do their own thing
54 min – an unthinking process of evolutionary trial and error has created these virtual creatures that can move/react in real time… what we’re seeing here.. is fantastic experimental evidence for the creative power of systems based on simple rules..
imagine if we let go of us.. we have no idea..
55 min – watching how computers can unconsciously evolve programs… to do things that no human could consciously program..is a fantastic ie of the power of self-org
indeed… let’s let go and give it a shot.. on us..
the simple rule is that the organism must replicate.. with a few random mutations now and again.. the feedback comes from the environment .. which favors the mutations that are best suited to it.. the result is ever increasing complexity.. produced without thought or design..
without thought/design/… prep.. B and b .. leaders.. et al
56 min – andrea: the interesting thing is that we can move up to a higher level of org.. once you have organisms that actually *have patterns on them.. selected for or against.. by feedbacks.. so evolution itself.. is in a sense.. touring in a game (?).. with feedbacks happening.. thru diff processes
*which is how we all come into the world..
and that’s the essence of this story… unthinking.. *simple rules.. have the power to create amazingly complex systems w/o any conscious thought.. in that sense.. these computer beings.. are self org’s systems .. just like the one belousov observed happening in his chemicals.. just like the ones in sand dunes and the mandelbrot sets.. lungs/hearts/weather/geography..
? hmm.. computer just like human/nature/living-orgs..? computer beings diff than nature.. bio.. no..? man made vs natural/alive..
ie: computer being need original program… nature/us already has that in us..
‘in undisturbed ecosystems ..the average individual, species, or population, left to its own devices, behaves in ways that serve and stabilize the whole..’ –Dana Meadows
57 min – designing does not need an acting/interfering designer.. it’s an inherent part of the universe
exactly… but not of man made techs.. saying otherwise.. reduces people/nature to that of a machine.. which is where this whole thing started.. no..? his clockwork mech.. not us..
andrea: one of things that makes people so uncomfortable about this idea of spontaneous pattern formation is that somehow or other.. *you don’t need a creator.. but perhaps a really clever designer.. what he would do kind of treat the universe like a giant simulation where you **set some condition and just let the whole thing spontaneously happen.. in all of its wonder/beauty
*ironic – need a creator for computer guy.. perhaps there is/was one for nature/us..
**my guess.. that’s how it/we were designed to be.. until we came in with our supposed to ness creating our not-us people.. our cancered planet.. most probably because of fear of the unpredictable..
ian: the mathematics of pattern formation..shows that the same kind of pattern can show up in an enormous range of diff physical/chemical/biological systems.. somewhere deep down inside it’s happening for the same mathematical reason.. implicit in those facts.. are these beautiful patterns that we see everywhere .. this i think is a mind blowing thought..
imagine 7 bn people set free to that.. as the day
58 min – so what is ultimate lesson we can take from all this..? well.. it’s that all the complexity of the universe.. all its infinite richness.. emerges from mindless simple rules repeated over and over again.. but remember.. powerful though this process is.. it’s also inherently unpredictable..
______
2015 tedgloballondon – How quantum biology might explain life’s biggest questions
i’m a nuclear physicist..
Nuclear physicists are scientists who study the structure and properties of nuclei in atoms and the forces that cause them to react. They use their knowledge of these atomic particles to operate power plants and create energy, light beams for X-ray machines and nuclear weapons.
______
find/follow Jim:
Physicist, author, broadcaster and humanist — The Universe doesn’t have a purpose, free will is an illusion, and quantum physics is beautiful. Now you know me.
his site:
Jameel Sadik “Jim” Al-Khalili OBE (Arabic: جميل صادق الخليلي; born 20 September 1962) is an Iraqi British theoretical physicist, author and broadcaster. He is currently Professor of Theoretical Physics and Chair in the Public Engagement in Science at the University of Surrey. He has presented a number of science programmes on BBC television and is a frequent commentator about science in other British media. In 2014 Al-Khalili was named as a RISE (Recognising Inspirational Scientists and Engineers) leader by the UK’s Engineering and Physical Sciences Research Council (EPSRC). He was President of the British Humanist Association between January 2013 and January 2016
______
while watching secret life of chaos.. intro’d to Iain McGilchrist – resonating.. but like so many.. saying let go.. while holding on.. ie.. in order to let go.. teach kids about history.. lit.. et al..
______